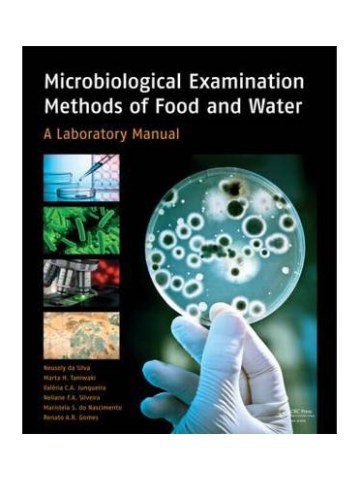
Microbiological Examination Methods of Food and Water (Μικροβιολογικές μέθοδοι ανάλυσης τροφίμων και νερού - έκδοση στα αγγλικά) Microbiological Examination Methods of Food and Water (Μικροβιολογικές μέθοδοι ανάλυσης τροφίμων και νερού - έκδοση στα αγγλικά)

Φίλτρα
Εκδοτικοί Οίκοι
Έτος έκδοσης
Κωδικός Βιβλίου στον Εύδοξο
Συγγραφέας(εις)
Τιμή Από - Έως (€)
Διαθεσιμότητα
1 - 104 / 104 (1 Σελ.)
ΚΩΔ. 025006
Tiμή Έκδοσης: 12,00€
10,80€
10,19€ + ΦΠΑ 6%
ΚΩΔ. 148001
Tiμή Έκδοσης: 12,23€
11,00€
10,38€ + ΦΠΑ 6%
ΚΩΔ. 023051
Tiμή Έκδοσης: 13,00€
11,70€
11,04€ + ΦΠΑ 6%
Tiμή Έκδοσης: 14,00€
12,60€
11,89€ + ΦΠΑ 6%
ΚΩΔ. 029041
Tiμή Έκδοσης: 17,00€
15,30€
14,43€ + ΦΠΑ 6%
ΚΩΔ. 023003
Tiμή Έκδοσης: 18,00€
16,20€
15,28€ + ΦΠΑ 6%
Tiμή Έκδοσης: 18,26€
16,43€
15,50€ + ΦΠΑ 6%
ΚΩΔ. 162017
Tiμή Έκδοσης: 20,00€
18,00€
16,98€ + ΦΠΑ 6%
ΚΩΔ. 028026
Tiμή Έκδοσης: 22,00€
19,80€
18,68€ + ΦΠΑ 6%
ΚΩΔ. 021029
Tiμή Έκδοσης: 23,00€
20,70€
19,53€ + ΦΠΑ 6%
ΚΩΔ. 014012
Tiμή Έκδοσης: 24,00€
21,60€
20,38€ + ΦΠΑ 6%
ΚΩΔ. 029036
Tiμή Έκδοσης: 25,00€
22,50€
21,23€ + ΦΠΑ 6%
ΚΩΔ. 001022
Tiμή Έκδοσης: 25,00€
22,50€
21,23€ + ΦΠΑ 6%
ΚΩΔ. 024079
Tiμή Έκδοσης: 25,88€
23,29€
21,97€ + ΦΠΑ 6%
ΚΩΔ. 014011
Tiμή Έκδοσης: 26,00€
23,40€
22,08€ + ΦΠΑ 6%
ΚΩΔ. 035018
Tiμή Έκδοσης: 26,62€
23,96€
22,60€ + ΦΠΑ 6%
ΚΩΔ. 033002
Tiμή Έκδοσης: 26,63€
23,97€
22,61€ + ΦΠΑ 6%
ΚΩΔ. 021037
Tiμή Έκδοσης: 26,63€
23,97€
22,61€ + ΦΠΑ 6%
ΚΩΔ. 001017
Tiμή Έκδοσης: 28,00€
25,20€
23,77€ + ΦΠΑ 6%
ΚΩΔ. 023007
Tiμή Έκδοσης: 28,00€
25,20€
23,77€ + ΦΠΑ 6%
ΚΩΔ. 021057
Tiμή Έκδοσης: 28,62€
25,75€
24,29€ + ΦΠΑ 6%
26,80€
25,28€ + ΦΠΑ 6%
Tiμή Έκδοσης: 30,74€
27,67€
26,10€ + ΦΠΑ 6%
ΚΩΔ. 002014
Tiμή Έκδοσης: 32,00€
28,80€
27,17€ + ΦΠΑ 6%
ΚΩΔ. 029006
Tiμή Έκδοσης: 32,00€
28,80€
27,17€ + ΦΠΑ 6%
ΚΩΔ. 374013
Tiμή Έκδοσης: 32,46€
29,21€
27,56€ + ΦΠΑ 6%
ΚΩΔ. 001103
Tiμή Έκδοσης: 34,00€
30,60€
28,87€ + ΦΠΑ 6%
ΚΩΔ. 002062
Tiμή Έκδοσης: 35,00€
31,50€
29,72€ + ΦΠΑ 6%
ΚΩΔ. 025053
Tiμή Έκδοσης: 37,28€
33,55€
31,65€ + ΦΠΑ 6%
ΚΩΔ. 162003
Tiμή Έκδοσης: 40,00€
36,00€
33,96€ + ΦΠΑ 6%
ΚΩΔ. 029042
Tiμή Έκδοσης: 42,00€
37,80€
35,66€ + ΦΠΑ 6%
ΚΩΔ. 023034
Tiμή Έκδοσης: 45,00€
40,50€
38,21€ + ΦΠΑ 6%
ΚΩΔ. 029037
Tiμή Έκδοσης: 50,00€
45,00€
42,45€ + ΦΠΑ 6%
ΚΩΔ. 029021
Tiμή Έκδοσης: 50,00€
45,00€
42,45€ + ΦΠΑ 6%
Tiμή Έκδοσης: 64,00€
48,00€
45,28€ + ΦΠΑ 6%
ΚΩΔ. 001160
Tiμή Έκδοσης: 55,00€
49,50€
46,70€ + ΦΠΑ 6%
ΚΩΔ. 001122
Tiμή Έκδοσης: 55,00€
49,50€
46,70€ + ΦΠΑ 6%
ΚΩΔ. 029039
Tiμή Έκδοσης: 56,00€
50,40€
47,55€ + ΦΠΑ 6%
ΚΩΔ. 025039
Tiμή Έκδοσης: 57,24€
51,52€
48,60€ + ΦΠΑ 6%
ΚΩΔ. 029038
Tiμή Έκδοσης: 60,00€
54,00€
50,94€ + ΦΠΑ 6%
ΚΩΔ. 029013
Tiμή Έκδοσης: 60,00€
54,00€
50,94€ + ΦΠΑ 6%
ΚΩΔ. 029020
Tiμή Έκδοσης: 60,00€
54,00€
50,94€ + ΦΠΑ 6%
ΚΩΔ. 029001
Tiμή Έκδοσης: 60,00€
54,00€
50,94€ + ΦΠΑ 6%
Tiμή Έκδοσης: 63,90€
57,51€
54,25€ + ΦΠΑ 6%
58,90€
55,57€ + ΦΠΑ 6%
ΚΩΔ. 001058
Tiμή Έκδοσης: 67,00€
60,30€
56,89€ + ΦΠΑ 6%
ΚΩΔ. 001050
Tiμή Έκδοσης: 90,00€
63,00€
59,43€ + ΦΠΑ 6%
ΚΩΔ. 028025
Tiμή Έκδοσης: 71,56€
64,40€
60,75€ + ΦΠΑ 6%
ΚΩΔ. 0040368
65,00€
61,32€ + ΦΠΑ 6%
ΚΩΔ. 029059
Tiμή Έκδοσης: 80,00€
72,00€
67,92€ + ΦΠΑ 6%
ΚΩΔ. 029035
Tiμή Έκδοσης: 90,00€
81,00€
76,42€ + ΦΠΑ 6%
ΚΩΔ. 022047
84,20€
79,43€ + ΦΠΑ 6%
85,00€
80,19€ + ΦΠΑ 6%
87,70€
82,74€ + ΦΠΑ 6%
ΚΩΔ. 029022
Tiμή Έκδοσης: 110,00€
99,00€
93,40€ + ΦΠΑ 6%
ΚΩΔ. 029040
Tiμή Έκδοσης: 110,00€
99,00€
93,40€ + ΦΠΑ 6%
ΚΩΔ. 029011
Tiμή Έκδοσης: 110,00€
99,00€
93,40€ + ΦΠΑ 6%
ΚΩΔ. 197002
102,50€
96,70€ + ΦΠΑ 6%
ΚΩΔ. 164001
Tiμή Έκδοσης: 117,15€
105,44€
99,47€ + ΦΠΑ 6%
ΚΩΔ. 164002
Tiμή Έκδοσης: 117,15€
105,44€
99,47€ + ΦΠΑ 6%
106,00€
100,00€ + ΦΠΑ 6%
ΚΩΔ. 197001
110,00€
103,77€ + ΦΠΑ 6%
ΚΩΔ. 005234
113,20€
106,79€ + ΦΠΑ 6%
113,50€
107,08€ + ΦΠΑ 6%
ΚΩΔ. 019126
117,50€
110,85€ + ΦΠΑ 6%
ΚΩΔ. 271020
120,00€
113,21€ + ΦΠΑ 6%
ΚΩΔ. 001123
Tiμή Έκδοσης: 135,00€
121,50€
114,62€ + ΦΠΑ 6%
ΚΩΔ. 015178
Tiμή Έκδοσης: 142,00€
127,80€
120,57€ + ΦΠΑ 6%
134,00€
126,42€ + ΦΠΑ 6%
135,00€
127,36€ + ΦΠΑ 6%
ΚΩΔ. 001108
Tiμή Έκδοσης: 154,00€
138,60€
130,75€ + ΦΠΑ 6%
ΚΩΔ. 186010
150,00€
141,51€ + ΦΠΑ 6%
ΚΩΔ. 019055
156,00€
147,17€ + ΦΠΑ 6%
ΚΩΔ. 186007
160,00€
150,94€ + ΦΠΑ 6%
ΚΩΔ. 005184
170,00€
160,38€ + ΦΠΑ 6%
ΚΩΔ. 186002
180,00€
169,81€ + ΦΠΑ 6%
ΚΩΔ. 004321
187,00€
176,42€ + ΦΠΑ 6%
195,92€
184,83€ + ΦΠΑ 6%
225,80€
213,02€ + ΦΠΑ 6%
231,50€
218,40€ + ΦΠΑ 6%
240,00€
226,42€ + ΦΠΑ 6%
ΚΩΔ. 019120
242,90€
229,15€ + ΦΠΑ 6%
242,90€
229,15€ + ΦΠΑ 6%
252,90€
238,58€ + ΦΠΑ 6%
264,50€
249,53€ + ΦΠΑ 6%
ΚΩΔ. 019058
275,95€
260,33€ + ΦΠΑ 6%
ΚΩΔ. 019026
287,35€
271,08€ + ΦΠΑ 6%
ΚΩΔ. 019008
303,70€
286,51€ + ΦΠΑ 6%
310,00€
292,45€ + ΦΠΑ 6%
318,50€
300,47€ + ΦΠΑ 6%
ΚΩΔ. 200001
676,70€
638,40€ + ΦΠΑ 6%
ΚΩΔ. 007100
Καλέστε για διαθεσιμότητα και τιμή
Καλέστε για διαθεσιμότητα και τιμή
ΚΩΔ. 029003
Καλέστε για διαθεσιμότητα και τιμή
ΚΩΔ. 002058
Καλέστε για διαθεσιμότητα και τιμή
ΚΩΔ. 001024
Καλέστε για διαθεσιμότητα και τιμή
ΚΩΔ. 220002
Καλέστε για διαθεσιμότητα και τιμή
ΚΩΔ. 002038
Καλέστε για διαθεσιμότητα και τιμή
ΚΩΔ. 023021
Καλέστε για διαθεσιμότητα και τιμή
Καλέστε για διαθεσιμότητα και τιμή
ΚΩΔ. 029002
Καλέστε για διαθεσιμότητα και τιμή
ΚΩΔ. 002042
Καλέστε για διαθεσιμότητα και τιμή
ΚΩΔ. 003018
Καλέστε για διαθεσιμότητα και τιμή
ΚΩΔ. 001048
Καλέστε για διαθεσιμότητα και τιμή